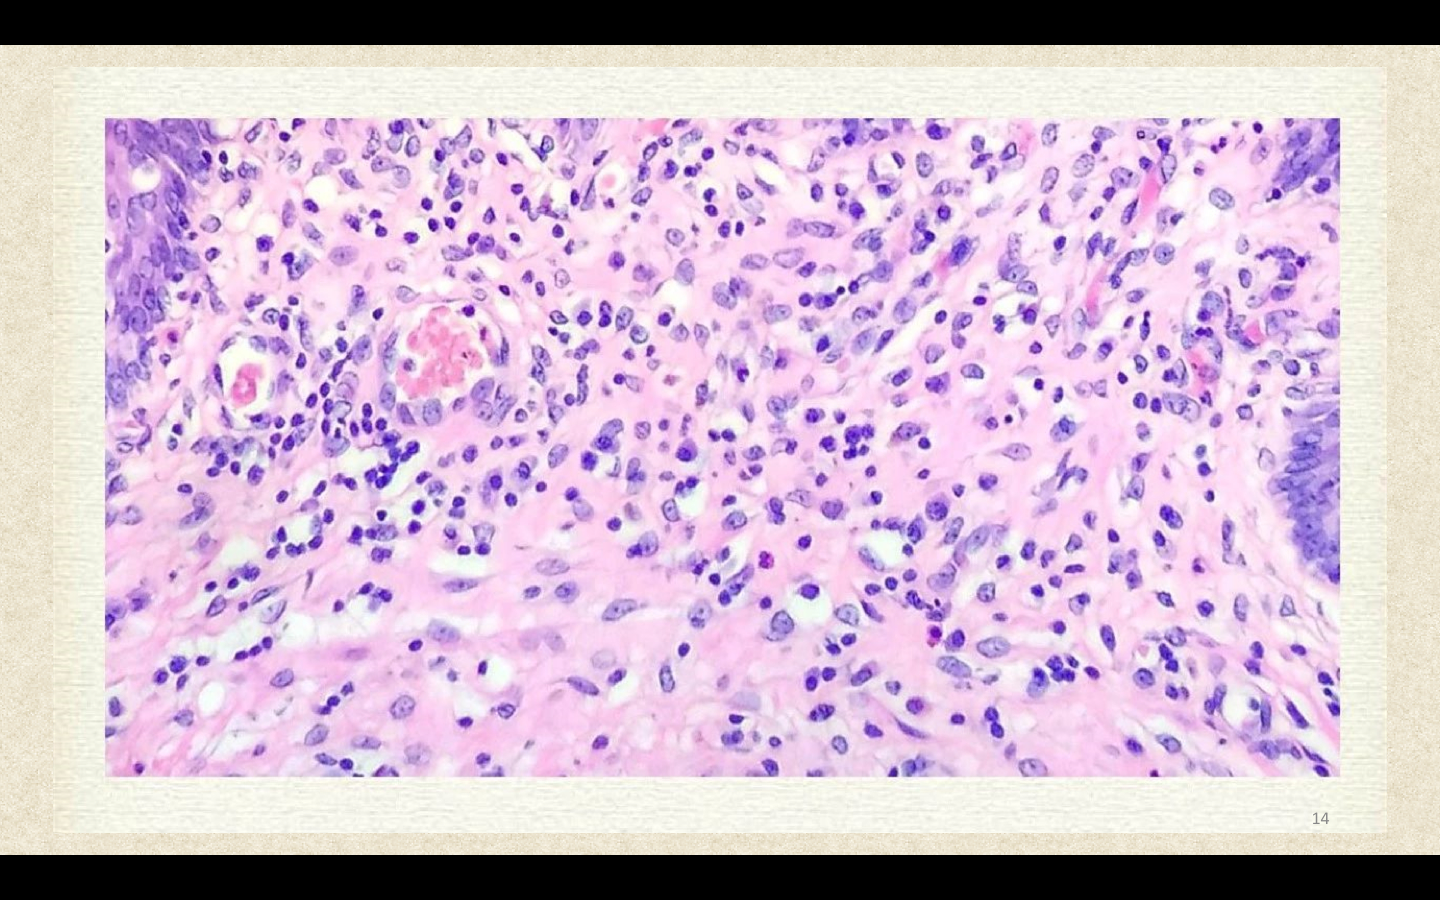

-
1 泌尿系统疾病概述...
-
2 肾脏和肾上腺的基...
-
3 膀胱和输尿管
-
4 前列腺
泌尿系统疾病概述-肾脏的结构和功能

泌尿系统包括肾脏、输尿管、膀胱和尿道。有下列几类疾病:①以肾小球损害为主的疾病;②以肾小管病变为主的疾病;③以肾间质病变为主的疾病;④以肾血管病变为主的疾病;⑤梗阻性肾脏疾病;⑥泌尿系统肿瘤;⑦先天性异常。其中肾脏疾病最为常见,特别是肾小球疾病,是重点内容,应充分理解肾小球疾病临床表现的病理学基础,并熟练掌握各型原发性肾小球疾病的临床病理特征。
肾脏是人体的重要排泄器官,其主要功能是过滤形成尿并排出代谢废物,调节体内的电解质和酸碱平衡。肾脏具有内分泌功能,通过产生肾素、促红细胞生成素、前列腺素、1,25-(OH)2D3等,参与调节血压、红细胞生成和钙的代谢。所以,肾的结构和功能异常,上述正常功能均可受到影响,出现一系列临床症状。
肾单位(nephron)是肾脏的基本结构和功能单位,由肾小球和其下属的近端肾小管、髓袢、远端肾小管组成。其中肾小球的结构和功能最复杂,通过毛细血管袢的过滤形成原尿,原尿流经肾小管时,通过吸收和浓缩,将原尿改造为终尿。肾小球(glomerulus)由两部分构成,即位于中央的血管球和位于周围的肾小囊。肾小囊(renal capsule or Bowman’s capsule)是肾小管盲端凹陷而成的双层囊,两层间的狭腔称为肾小囊腔(urinary space)。肾小囊的外层由单层扁平上皮构成,在肾小球尿极处与近端肾小管上皮相连。在血管极处,外层细胞反折延续成肾小囊内层,紧包在成簇的毛细血管袢的外面。血管球是一团蟠曲成球状的毛细血管。一条入球小动脉由血管极处进入肾小球后反复分支形成互相吻合的毛细血管袢,最后又在血管极处汇成一条出球小动脉。

电镜观察,肾小球毛细血管壁有三层结构,中间为基底膜,内侧衬以内皮细胞(endothelium),外侧被以上皮细胞(epithelium),即肾小囊内层上皮细胞。毛细血管袢之间有支持毛细血管的系膜(mesangium)。系膜区域有系膜细胞(mesangial cell)和系膜基质(mesangial matrix)充填在各叶毛细血管之间,构成毛细血管袢的轴心,在正常3μm的切片下,一个系膜区有1~2个系膜细胞。系膜基质是系膜细胞的产物,结构与基底膜致密层相似,但电子密度稍低。
 |  |
肾小囊内层上皮细胞就是通常所说的肾小球上皮细胞,又称足细胞(podocyte),其形态特殊,胞体的一部分伸出并形成足状突起,紧贴在基底膜外侧。足突和足突之间有一裂隙,宽约25nm,称为裂孔(slit pore),裂孔上有厚约4~6nm的膜,称为裂孔膜(slit membrane)。裂孔膜实际上是足细胞单位膜最外面的一层。许多疾病状态下,足突相互融合,裂孔消失。基底膜(glomerular basement membrane)由三层构成,中间一层电子密度高,称致密层;内外两侧电子密度低,分别称为内、外疏松层。急速冷冻深度蚀刻电镜技术观察表明,基底膜致密层是由细纤维构成的网状构造,与上皮细胞和内皮细胞之间由垂直的架桥细纤维连接。
| 肾小球超微结构 Fp:足突 Bm:基底膜 Ed:内皮细胞 | 肾小球基底膜网状构造 |
 |  |
免疫复合物性肾小球肾炎时,内外疏松层常有免疫复合物沉积。正常基底膜厚约250nm,某些疾病时,其厚度可增加2倍以上。内皮细胞位于基底膜内侧,胞浆很薄且布满小孔,小孔无隔膜,孔径50~100nm。通常把有孔的内皮细胞、基底膜和上皮细胞的裂孔膜三层结构称为滤过膜(filtration membrane)或滤过屏障(filtration barrier)。另外,基底膜内外疏松层,特别是外疏松层,有大量主要由硫酸类肝素多糖蛋白(heparan sulfate proteoglycan)构成的负电荷位点,可阻止血中带负电荷的低分子物质通过基底膜,称之为电荷选择屏障(charge- selective barrier)。
|